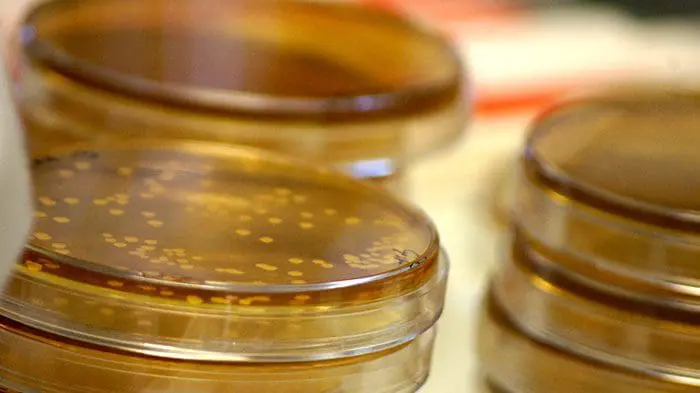

Le saviez vous? Notre corps héberge 100 000 milliards de micro-organismes, cela représente 10 fois plus de bactéries que de cellules !
Le microbiote représente l’ensemble de ces micro-organismes. Aujourd’hui les équipes de l’Institut Pasteur de Lille travaillent sur les liens entre le microbiote et les maladies métaboliques. L’équipe du docteur Grangette observe comment les changements de la composition du microbiote s’effectuent afin de développer de nouveaux outils thérapeutiques.

Un écosystème complexe
Le microbiote représente l’ensemble des micro-organismes présents dans notre corps. On parle souvent du microbiote intestinal, mais nous possédons également un microbiote oro-pharyngé, cutané ou encore vaginal. Le microbiote est très complexe ; il y a encore une quinzaine d’années, les chercheurs n’avaient qu’une vision très fragmentée de sa composition.
Aujourd’hui, grâce aux techniques OMICs, dont les nouvelles technologies de séquençage haut débit font parties, les chercheurs se sont aperçus que l’on ne connaissait qu’une petite partie de sa fonction, « c’est à dire le sommet de l’iceberg, toute la partie immergée restant encore à découvrir et à comprendre » explique le Dr Corinne Grangette, Directrice de recherche au Centre d’Infection et d’Immunité de Lille du Campus Pasteur Lille. Notre corps héberge environ 100 000 milliards de micro-organismes, ce qui représente 10 fois plus de bactéries que nos propres cellules. Nous sommes ainsi composés à 90% de bactéries (en nombre de cellules). Plus de 1 000 espèces différentes sont exprimées pour toute la population et une cinquantaine d’espèces est retrouvée chez plus de la moitié des individus. Les « 1 000 premiers jours de notre vie » sont cruciaux pour notre développement.
Cette période des origines développementales de la Santé (DOHaD ) s’étend de la grossesse (in utero) jusqu’à la fin des 2 ans de l’enfant. Dans ce contexte, la fenêtre d’implantation du microbiote qui s’établit dès les premiers jours suivant la naissance joue également un rôle important sur le développement des fonctions de l’intestin notamment du système immunitaire. La manière dont l’enfant naît (césarienne, voie naturelle), son alimentation (lait maternel, lait maternisé…), son environnement, sont autant de facteurs pouvant impacter la composition du microbiote et de ce fait avoir une influence à long terme. L’alimentation de la mère a également des répercussions sur le développement de l’enfant, pouvant influencer son métabolisme.
Comprendre le microbiote pour agir
Chaque microbiote est unique. Il est constitué par de grands groupes de bactéries, mais sa composition est variable d’un individu à l’autre, un peu comme une « empreinte génétique », souligne le Dr Grangette.
Depuis 50 ans, l’incidence des pathologies chroniques (maladies inflammatoires chroniques de l’intestin, obésité, diabète, cancers…) augmente, sans doute en raison de changement de style de vie et d’excès d’hygiène. Ces maladies chroniques sont associées à des changements de la composition du microbiote et une chute de la diversité des bactéries: on parle alors de dysbiose. L’enjeu est donc de mieux comprendre ces changements et d’avoir une vision plus claire du rôle du microbiote pour pouvoir y pallier.
Aujourd’hui, les recherches ne permettent pas d’affirmer si les modifications du microbiote sont à l’origine de pathologie ou si la pathologie est à l’origine des modifications du microbiote. « Il est difficile de déterminer qui est la poule et qui est l’œuf » commente le Dr Grangette. Elle explique que le déséquilibre peut être transférable, par exemple si l’on transfert le microbiote d’un donneur obèse dans un hôte stérile c’est-à-dire sain, la pathologie est transférée. « Les échanges sont dynamiques et se font très certainement dans les deux directions, mais les origines restent pour l’heure obscures ». Des polymorphismes génétiques peuvent, par exemple, influencer le microbiote, qui va lui-même influencer la pathologie, c’est un équilibre à deux sens.
Les chercheurs tentent maintenant de cibler les dysbioses du microbiote comme outil thérapeutique. Dans les cas les plus extrêmes, un transfert de flore intestinale peut être réalisé, mais l’utilisation de prébiotiques (fibres non digestives favorisant la croissance de certaines bactéries du microbiote) ou de probiotiques (microorganismes ayant des propriétés bénéfiques pour l’hôte) connaît actuellement un fort engouement. L’équipe du Dr Corinne Grangette se focalise sur l’étude de ces microorganismes probiotiques.
Une équipe de recherche dédiée aux probiotiques
De nouvelles pistes de développement
Grâce aux projets développés dans le cadre du Centre Transdisciplinaire de Recherche sur la Longévité, l’équipe va amorcer des recherches sur la stéatose hépatique non alcoolique (NASH), en collaboration avec une équipe de l’Unité dirigée par le Pr Bart Staels à l’Institut Pasteur de Lille. La stéatose hépatique non alcoolique étant une cirrhose du foie non liée à la consommation d’alcool, mais à la consommation de sucre, cette cirrhose peut évoluer vers un cancer du foie. Les chercheurs s’appliqueront à comprendre l’influence des probiotiques sur cette pathologie touchant 20% des adultes français.
L’équipe travaille également en partenariat avec l’INRA (Institut National de Recherche Agronomique), pour étudier les propriétés fonctionnelles de bactéries isolées de microbiote humain et capables d’être cultivées dans des conditions satisfaisantes (la majorité étant incultivables). Un nouveau domaine de recherche s’ouvre par cette collaboration : comprendre la fonction des bactéries du microbiote pour les utiliser comme probiotique de nouvelle génération.
Le Dr Grangette souhaite également développer un pan de recherche sur l’impact de la colonisation périnatale (concept de DOHaD) par des bactéries probiotiques et évaluer l’impact à l’âge adulte sur le développement de maladies chroniques.
Découvertes
Le microbiote intestinal renforce la chimiothérapie
Des travaux récents menés par le Dr Mathias Chamaillard à l’Institut Pasteur de Lille en lien avec une équipe de Gustave Roussy ont montré que deux espèces bactériennes présentes dans l’intestin peuvent activer les cellules de l’immunité et booster l’efficacité d’un médicament anticancéreux fréquemment prescrit.
Leur étude identifie le rôle de Enteococcus hirae et Barenesiella intestinihominis dans l’activation des réponses immunitaires à lymphocytes T luttant contre le cancer. Ces bactéries intestinales renforcent les effets du cyclophosphamide, un médicament de chimiothérapie. De plus, la réponse immunitaire renforcée par les bactéries permet de prédire, chez les patients atteints d’un cancer du poumon ou de l’ovaire à un stade avancé et traités par chimio-immunothérapie, une survie (sans progression de la maladie) plus longue. Un bel exemple d’une découverte permettant de vivre mieux plus longtemps !
Microbiote et horloge interne
L’équipe dirigée par le Dr Mathias Chamaillard a mis en évidence un rôle déterminant de l’interaction entre l’horloge interne et la flore commensale ce qui ouvre des perspectives encourageantes en chronopharmacologie. Elle a montré qu’une accumulation de bactéries dont l’abondance oscille en fonction du rythme circadien corrèle avec des altérations de l’expression de nombreux acteurs clefs du système d’horloge interne ce qui conditionne de nombreux processus vitaux de notre organisme comme les défenses anti-infectieuses, le métabolisme du glucose et l’efficacité de traitements. Elle a montré l’importance de la composition de la flore intestinale sur les propriétés anti-inflammatoires et anti-prolifératives d’un composé chimique de la famille des flavonoïdes largement présent dans les fruits et légumes et qui se trouve influencer l’horloge interne.




















